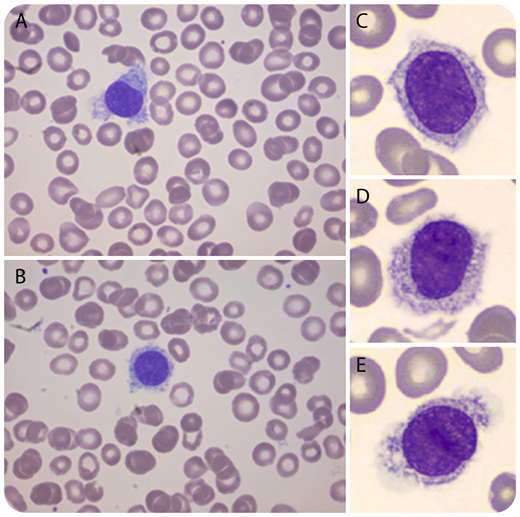
A 16-year-old boy was referred by his general practitioner to a pediatrician because of thrombocytopenia (30 × 109/L) discovered in a routine blood count, which was performed before initiation of treatment with isotretinoin. He had no physical complaints or bleeding tendency. Physical examination revealed no hepatosplenomegaly or lymphadenopathy, and peripheral blood analysis demonstrated a moderate thrombocytopenia, mild neutropenia, mild normocytic anemia, and normal biochemical analysis. Additional microscopic evaluation revealed 17% atypical lymphocytes with hairy projections, suggestive for hairy cell leukemia (HCL) (panels A-E, original magnification ×1000; May-Grünwald Giemsa stain). A bone marrow examination was performed, demonstrating diffuse infiltration of mature B cells immunophenotypically characterized by CD19, CD20, CD22, and FMC7 expression and, to a lesser extent, expression of CD103 and CD11c. Molecular analysis demonstrated a BRAF V600E mutation, strongly supporting the diagnosis of HCL. / HCL is a rare chronic B-cell malignancy accounting for 2% of all leukemias. HCL is predominantly diagnosed in patients >50 years of age and is extremely rare in children, as illustrated by only 3 cases described in the literature. Intriguingly, our patient was diagnosed with HCL following a random hematological evaluation (required to start with isotretinoin therapy) and did not show typical characteristics of HCL, such as hepatosplenomegaly, pancytopenia, and monocytopenia, suggesting a very early diagnosis.

A 16-year-old boy was referred by his general practitioner to a pediatrician because of thrombocytopenia (30 × 109/L) discovered in a routine blood count, which was performed before initiation of treatment with isotretinoin. He had no physical complaints or bleeding tendency. Physical examination revealed no hepatosplenomegaly or lymphadenopathy, and peripheral blood analysis demonstrated a moderate thrombocytopenia, mild neutropenia, mild normocytic anemia, and normal biochemical analysis. Additional microscopic evaluation revealed 17% atypical lymphocytes with hairy projections, suggestive for hairy cell leukemia (HCL) (panels A-E, original magnification ×1000; May-Grünwald Giemsa stain). A bone marrow examination was performed, demonstrating diffuse infiltration of mature B cells immunophenotypically characterized by CD19, CD20, CD22, and FMC7 expression and, to a lesser extent, expression of CD103 and CD11c. Molecular analysis demonstrated a BRAF V600E mutation, strongly supporting the diagnosis of HCL.
HCL is a rare chronic B-cell malignancy accounting for 2% of all leukemias. HCL is predominantly diagnosed in patients >50 years of age and is extremely rare in children, as illustrated by only 3 cases described in the literature. Intriguingly, our patient was diagnosed with HCL following a random hematological evaluation (required to start with isotretinoin therapy) and did not show typical characteristics of HCL, such as hepatosplenomegaly, pancytopenia, and monocytopenia, suggesting a very early diagnosis.
A 16-year-old boy was referred by his general practitioner to a pediatrician because of thrombocytopenia (30 × 109/L) discovered in a routine blood count, which was performed before initiation of treatment with isotretinoin. He had no physical complaints or bleeding tendency. Physical examination revealed no hepatosplenomegaly or lymphadenopathy, and peripheral blood analysis demonstrated a moderate thrombocytopenia, mild neutropenia, mild normocytic anemia, and normal biochemical analysis. Additional microscopic evaluation revealed 17% atypical lymphocytes with hairy projections, suggestive for hairy cell leukemia (HCL) (panels A-E, original magnification ×1000; May-Grünwald Giemsa stain). A bone marrow examination was performed, demonstrating diffuse infiltration of mature B cells immunophenotypically characterized by CD19, CD20, CD22, and FMC7 expression and, to a lesser extent, expression of CD103 and CD11c. Molecular analysis demonstrated a BRAF V600E mutation, strongly supporting the diagnosis of HCL.
HCL is a rare chronic B-cell malignancy accounting for 2% of all leukemias. HCL is predominantly diagnosed in patients >50 years of age and is extremely rare in children, as illustrated by only 3 cases described in the literature. Intriguingly, our patient was diagnosed with HCL following a random hematological evaluation (required to start with isotretinoin therapy) and did not show typical characteristics of HCL, such as hepatosplenomegaly, pancytopenia, and monocytopenia, suggesting a very early diagnosis.
For additional images, visit the ASH Image Bank, a reference and teaching tool that is continually updated with new atlas and case study images. For more information, visit http://imagebank.hematology.org.